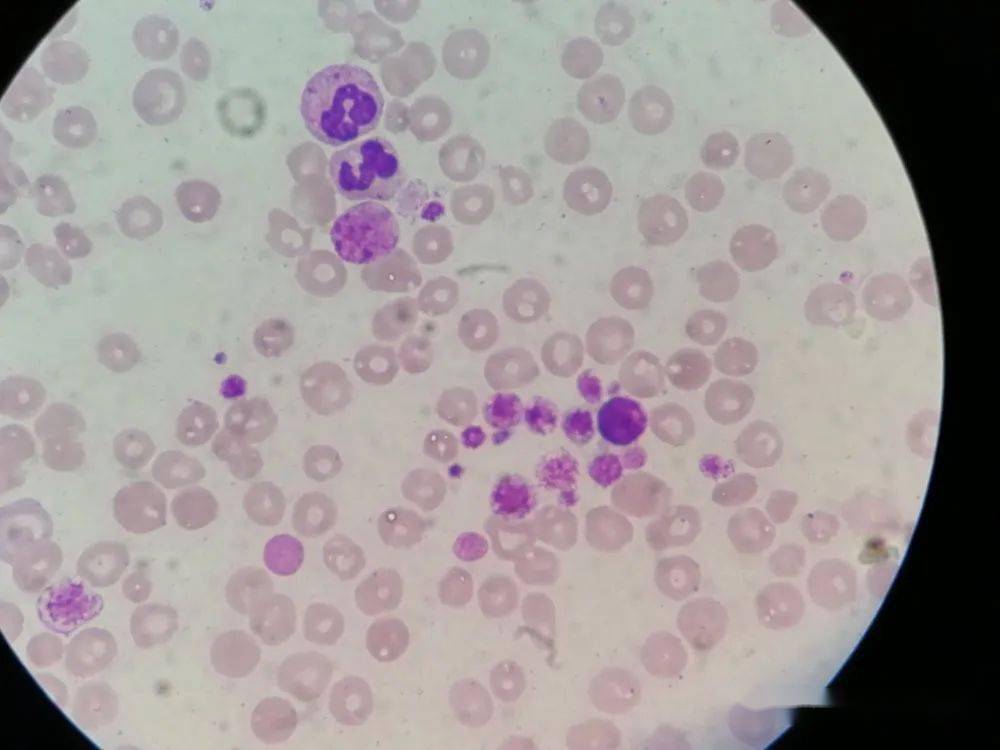
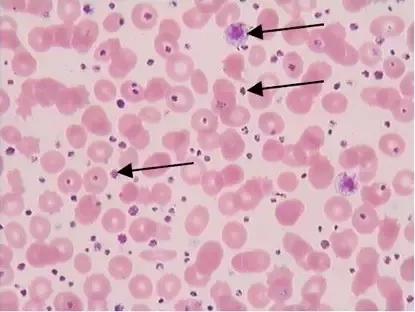

原发性血小板增高症的中医治疗一例
- 民间偏方
- 2022-08-17
- 1130
原发性血小板增多症(ET)属骨髓增殖性疾病(MPD)范畴,临床有外周血血小板明显增多为特征,常出现自发出血倾向或血栓形成。ET骨髓象有核细胞增生活跃,巨核细胞增生尤为明显,以大的成熟巨核细胞为特征,有大量血小板聚集,故易形成血栓。由于血小板功能多有异常,故出血时间延长,凝血酶原消耗时间缩短,故有出血倾向。诊断时应注意与继发性血小板增多症和其他MPD相鉴别。治疗应以使血小板减少至正常或接近正常为目的,同时预防血栓和出血。山东中医药大学附属医院血液病科徐瑞荣
患者邢某,女,26岁,两年前确诊为血小板增多症。2016年9月29日来我院复诊。患者病史同前,舌质红,剥落苔,偶有头痛,月经量少,纳眠可,小便调,大便稀,日3次。血象:WBC7.66x10^9/L, Hb 126g/L ,^9/L ,RBC 3.6x10^12/L。
中医辨证:阴虚血瘀证
治法治则:养阴清热,活血化瘀。

处方:

中药方:
丹参30g 川芎9g 荔枝核15g 荜澄茄15g 知母15g 熟地黄15g 天门冬15g 薏苡仁15g 茯苓30g 山药30g 黄柏15g鳖甲30 青蒿18g 漏芦15g 夏枯草15g
处方分析:方中以熟地黄,天门冬,知母,山药滋阴补津;同时患者有阴虚化热征象,故加黄柏,鳖甲,青蒿,漏芦,夏枯草除虚热,退骨蒸,益阴津,凉血热;加丹参,川芎活血化瘀;依据“气行则血形”“血为气之母,气为血之帅”等中医对气血津液系统的认识,加入荔枝核,荜澄茄行气以助血行,同时可以止痛缓解病人痛苦;薏苡仁,茯苓,山药可以健脾除湿,补益脾胃,治疗大便稀溏。本方在养阴清热的同时,以行血行气活血化瘀,加入熟地补血养血以防行气行血而耗血动血,充分体现了中医辨证论治,处方灵活,标本兼顾,治病求本的治疗特色。
发表评论